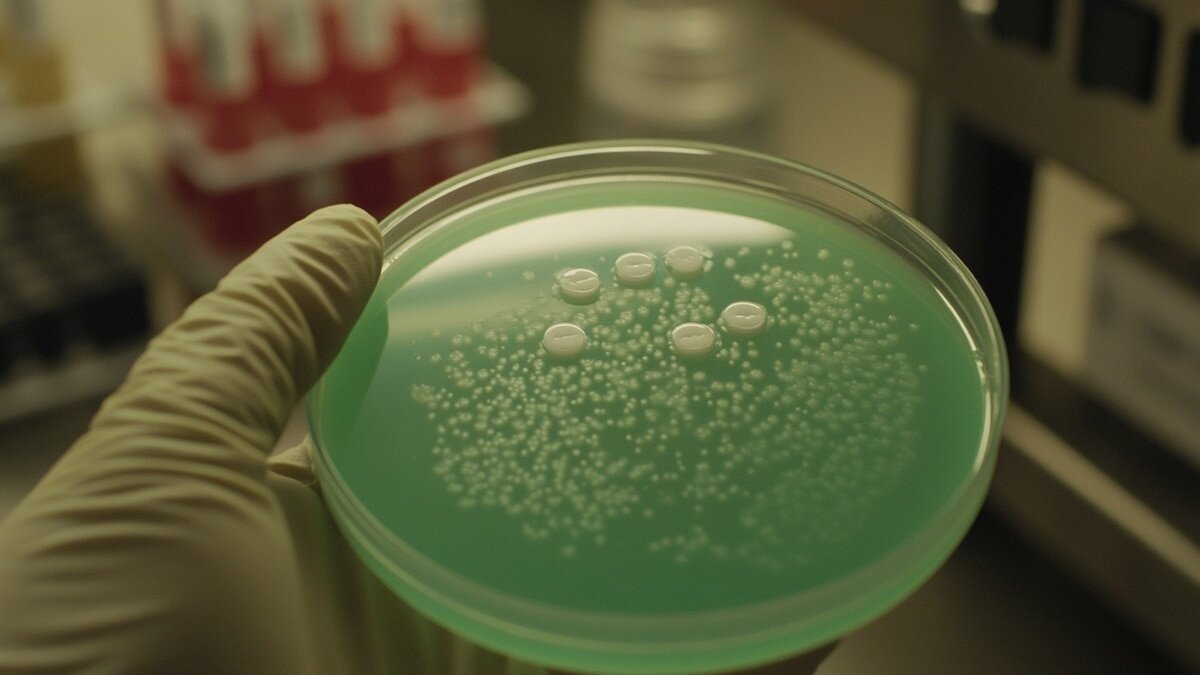

Diabetes: cómo las superbacterias desafían los tratamientos de infecciones
El pie diabético es una complicación crónica que puede afectar a personas con diabetes y se desarrolla cuando el daño en los nervios se combina con problemas en la circulación sanguínea. Esta combinación favorece la aparición de úlceras, infecciones y destrucción del tejido del pie, con un alto riesgo de amputación si no se brinda atención oportuna.
Un grupo de científicos del Reino Unido identificó que las infecciones asociadas al pie diabético presentan una elevada diversidad genética de la bacteria Escherichia coli. Además, se detectó la presencia de múltiples cepas con resistencia a diversos antibióticos, conocidas comúnmente como superbacterias.
Este descubrimiento obliga a replantear los métodos de diagnóstico y las estrategias terapéuticas actuales, ya que la complejidad bacteriana puede dificultar el tratamiento y favorecer la progresión de la enfermedad.
El estudio, publicado en la revista Microbiology Spectrum, reveló que no existe una sola variante de E. coli implicada en estas infecciones, sino numerosos linajes capaces de sobrevivir y adaptarse dentro de las heridas crónicas del pie diabético. Esta diversidad patogénica sugiere la necesidad de enfoques médicos más personalizados para cada paciente.
La investigación fue llevada a cabo por especialistas del King’s College de Londres y la Universidad de Westminster. Para el análisis, se utilizaron muestras de pacientes provenientes de diez países, entre ellos Nigeria, Ghana, Suecia, Malasia, China, Corea del Sur, Brasil, India y Estados Unidos.
El pie diabético se origina por la pérdida de sensibilidad y la mala cicatrización derivadas del daño nervioso y vascular. Esto incrementa el riesgo de infección y acelera el deterioro del tejido, lo que puede llevar a amputaciones si no se actúa con rapidez.
Con el objetivo de determinar si ciertos linajes de E. coli provocan infecciones más agresivas o resistentes, los investigadores secuenciaron el genoma completo de 42 cepas aisladas de úlceras infectadas. El análisis permitió comparar los microorganismos e identificar genes asociados a la resistencia antimicrobiana.
Los resultados mostraron la existencia de siete grupos filogenéticos y 28 tipos distintos de secuencia genética, evidenciando una diversidad considerable. El estudio del pangenoma reveló más de 18 mil grupos de genes, de los cuales solo unos 2,400 estaban presentes en todas las cepas, mientras que más de 11 mil eran exclusivos de ciertos aislados.
El 78% de las muestras analizadas fue clasificado como multidrogorresistente o extremadamente resistente. Se identificaron genes que confieren resistencia a antibióticos de uso común y, en algunos casos, incluso a medicamentos considerados de última línea, como la colistina y los carbapenémicos.
Los investigadores concluyeron que no existe un antibiótico único eficaz contra todas las cepas estudiadas, lo que complica el manejo clínico de estas infecciones. Asimismo, se detectaron genes que facilitan la adhesión bacteriana a los tejidos y la evasión del sistema inmunológico, explicando la persistencia y gravedad de muchas infecciones del pie diabético.
ENFERMEDADES: Qué mosquitos transmiten la malaria y cómo protegerte
Un zumbido casi imperceptible al caer la noche puede representar el inicio de un problema de salud global: la malaria. Los mosquitos que la transmiten no son solo insectos molestos, sino vectores altamente eficientes capaces de introducir parásitos directamente en el organismo -- leer más
Noticias del tema